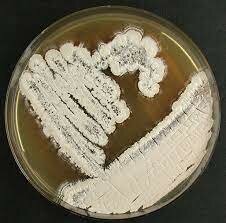
Albert Schatz

Línea del tiempo de la microbiología_Ortiz Huerta Andrea Noemi. MICROBIOLOGÍA APLICADA DO3 2023A
By Andrea.x.
-
 Fue el primero en refutar la teoría de la generación espontánea en gusanos.
Fue el primero en refutar la teoría de la generación espontánea en gusanos. -
 Es el primero en observar bacterias o "animálculos".
Es el primero en observar bacterias o "animálculos". -
 Desarrolla la primera vacuna contra la viruela humana.
Desarrolla la primera vacuna contra la viruela humana. -
 Propone la utilización de antisépticos para evitar la fiebre puerperal.
Propone la utilización de antisépticos para evitar la fiebre puerperal. -
 Demuestra que el carbunco o ántrax es causado por Bacillus anthracis
Demuestra que el carbunco o ántrax es causado por Bacillus anthracis -
 Las tinciones en microbiología son las primeras herramientas que se utilizan en el laboratorio para el diagnóstico de las enfermedades infecciosas.
Las tinciones en microbiología son las primeras herramientas que se utilizan en el laboratorio para el diagnóstico de las enfermedades infecciosas. -
 Puso a punto una vacuna contra la rabia.
Puso a punto una vacuna contra la rabia. -
 Descubre Escherichia coli.
Descubre Escherichia coli. -
 Aísla bacterias fijadoras de nitrógeno de los nódulos presentes en las raíces de leguminosas.
Aísla bacterias fijadoras de nitrógeno de los nódulos presentes en las raíces de leguminosas. -
 Demuestra que el mosaico del tabaco es producido por un virus.
Demuestra que el mosaico del tabaco es producido por un virus. -
 Confirma que la fiebre amarilla es transmitida por mosquitos, hecho previamente observado por Carlos Finlay en 1881.
Confirma que la fiebre amarilla es transmitida por mosquitos, hecho previamente observado por Carlos Finlay en 1881. -
 Demuestra que la fiebre de las Montañas Rocosas es transmitida por garrapatas, y aisló el microorganismo causante de la enfermedad (que él llamó rickettsia). Falleció por esa enfermedad.
Demuestra que la fiebre de las Montañas Rocosas es transmitida por garrapatas, y aisló el microorganismo causante de la enfermedad (que él llamó rickettsia). Falleció por esa enfermedad. -
 Descubre el salvarsán (balas mágicas), primer agente quimioterapéutico contra la sífilis.
Descubre el salvarsán (balas mágicas), primer agente quimioterapéutico contra la sífilis. -
 Descubre el virus (retrovirus) que produce tumores (sarcomas) en pollos.
Descubre el virus (retrovirus) que produce tumores (sarcomas) en pollos. -
 Descubre los virus que infectan bacterias (bacteriófagos).
Descubre los virus que infectan bacterias (bacteriófagos). -
Aísla la penicilina de un cultivo de Penicillium notatum.
-
 Descubre las sulfamidas, el primer agente quimioterapéutico.
Descubre las sulfamidas, el primer agente quimioterapéutico. -
Aísla la estreptomicina de un cultivo de Streptomyces griseus. Su jefe, Selman Waksman, se apodera del descubrimiento y gana el premio Nobel de Medicina de 1952.
-
 Descubren que el codón UUU codificaba para el aminoácido fenilalanina, experimento que sentó las bases para la elucidación del código genético.
Descubren que el codón UUU codificaba para el aminoácido fenilalanina, experimento que sentó las bases para la elucidación del código genético. -
Pone a punto un test bacteriano para detectar mutágenos y carcinógenos: el test de Ames.
-
 Demuestran el papel de Helicobacter pylori en la úlcera de estómago.
Demuestran el papel de Helicobacter pylori en la úlcera de estómago. -
 Llevan a cabo el aislamiento e identificación del virus del sida.
Llevan a cabo el aislamiento e identificación del virus del sida. -
 Se secuencia el genoma de la bacteria Escherichia coli.
Se secuencia el genoma de la bacteria Escherichia coli. -
 Descubren que Vibrio cholerae tiene dos cromosomas circulares.
Descubren que Vibrio cholerae tiene dos cromosomas circulares. -
 Secuenciación del genoma de Legionella pneumophila, el microorganismo productor de la enfermedad de los legionarios.
Secuenciación del genoma de Legionella pneumophila, el microorganismo productor de la enfermedad de los legionarios. -
Bacillus subtilis puede producir dos esporas en la misma célula madre.
-
 Caracterización "in vivo" e "in vitro" del virus H1N1.
Caracterización "in vivo" e "in vitro" del virus H1N1.
A list shows items. A timeline shows sequence.
Use Timetoast to make dates, milestones, and turning points easier to understand in a clear visual format. Timetoast is a timeline maker for work, school, research, and stories.